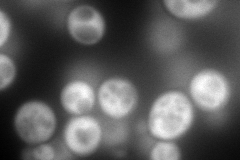
YER081W
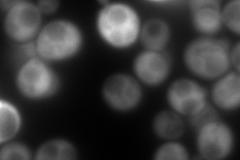
YER081W
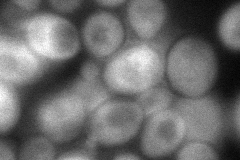
YER081W
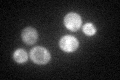
YER081W

View description
3-phosphoglycerate dehydrogenase, catalyzes the first step in serine and glycine biosynthesis; isozyme of Ser33p
Localization:
Intensity:
Fold change:
Significance:
-
C’ GFP library in SD

cytosol43.19 -
N' NOP1pr-GFP in SD
cytosol280.988 -
N' TEF2pr-mCherry in SD
cytosol442.659 -
N' NATIVEpr-GFP in SD

cytosol55.1462 -
N' TEF2pr-VC and Cyto-VN in SD
cytosol77.6841 -
C’ GFP library in SD+DTT

cytosol74.781.73Yes -
C’ GFP library in SD+H2O2

cytosol59.481.37Yes -
C’ GFP library in Starvation Media
cytosol67.641.56Yes -
C’ GFP library on the background of Pup2-DaMP

cytosol -
C’ GFP library on the background of CCT mutant

cytosol63.1651.46223Yes
